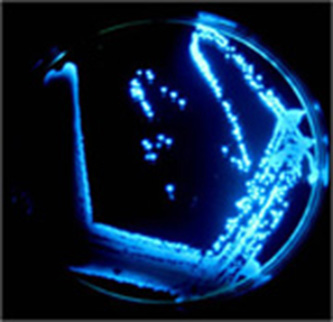

Luminescence
Luminescence is spontaneous emission of light by a substance not resulting from heat. It can be caused by chemical reactions, electrical energy, subatomic motions or stress on a crystal. This distinguishes luminescence from incandescence, which is light emitted by a substance as a result of heating. Historically, radioactivity was thought of as a form of "radio-luminescence", although it is today considered to be separate since it involves more than electromagnetic radiation.

Firefly-Luciferase
Bioluminescence
Bioluminescence is the production and emission of light by a living organism. It is a form of chemi-luminescence. Bioluminescence occurs widely in marine vertebrates and invertebrates, as well as in some fungi, microorganisms including some bioluminescent bacteria and terrestrial invertebrates such as fireflies.
In some animals, the light is bacteriogenic, produced by symbiotic organisms such as Vibrio bacteria; in others, it is autogenic, produced by the animals themselves.
Bioluminescent bacteria
Bioluminescent bacteria are light-producing bacteria that are predominantly present in sea water, marine sediments, the surface of decomposing fish and in the gut of marine animals. While not as common, bacterial bioluminescence is also found in terrestrial and freshwater bacteria. These bacteria may be free living (such as Vibrio harveyi) or in symbiosis with animals such as the Hawaiian Bobtail squid (Aliivibrio fischeri) or terrestrial nematodes (Photorhabdus luminescens).
The host organisms provide these bacteria a safe home and sufficient nutrition. In exchange, the hosts use the light produced by the bacteria for camouflage, prey and/or mate attraction. Bioluminescent bacteria have evolved symbiotic relationships with other organisms in which both participants benefit close to equally. Another possible reason that bacteria use luminescence reaction is for quorum sensing, an ability to regulate gene expression in response to bacterial cell density.
Luciferase
Luciferase is a generic term for the class of oxidative enzymes that produce bioluminescence, and is usually distinguished from a photoprotein.

Luciferin
Luciferin (from the Latin lucifer, "light-bringer") is a generic term for the light-emitting compound found in organisms that generate bioluminescence. Luciferins typically undergo an enzyme-catalyzed oxidation and the resulting excited state intermediate emits light upon decaying to its ground state. This may refer to molecules that are substrates for both luciferases and photoproteins. Under certain conditions sea-algae illuminate.

Counter-illumination
Counter-illumination is a method of active camouflage seen in marine animals such as firefly squid and midshipman fish, and in military prototypes, producing light to match their backgrounds in both brightness and wavelength.